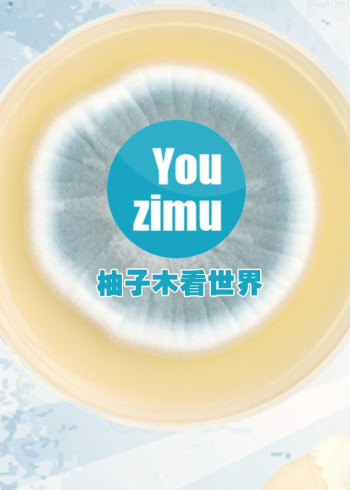
柚子木看世界

发现"Yo"14311部影视剧集
电影
超清

2024/英国/英国,2016,灾难
美国路易斯安那州的奇特湿地是人们向往的地方,作为自然栖息地和天然渔场,那里的湿地非常珍贵,人们说如果没有湿地就没有路易斯安那州的存在,然而,今年年初一个事件震惊了全球,把这片乐园推入险境并触发一连串的连锁反应可能影响全球亿万居民的正常生活!
电影
超清

2015/英国/英国,2015,旅游
七年前,主持人史蒂芬·弗莱(Stephen Fry)乘坐一辆伦敦的出租车,游历了美国的50个州。然而他一直以来就对美国国境以南的事情着迷,所以在这部四集系列片中,他将踏上一段新的旅程。从墨西哥出发,穿越整个中美洲地区,最终达到与南美洲接壤的巴拿马边界,这是一个遇见许多世界上最古老的文明的旅程。
电影
超清

2024/英国/英国,2016,医疗健康
急救人员是第一时间到达紧急事件现场的人,每一年,他们的速度和专业都关系到上千条生命。这档情节紧凑的节目拍摄了一群年轻人在竞争最激烈、最激动人心和要求最高的职业道路上努力拼搏的历程。为了取得急救人员资格证,他们需要接受两年的培训。本节目拍摄了处于培训各个不同阶段的急救学员们。他们工作在英国国家医疗服务体系前线,从第一天开始,他们就要面对多种内容的工作,从快速行车技能,到节假日处理药物过量的病患,再到交通事故中的救生护理。无论学员们在工作还是娱乐,镜头一直伴随他们。作为压力巨大的急救人员,这些新人如何应对紧张的学习任务和作为救护车急救人员的高压力的实践训练呢?
电影
超清

2014/英国/英国,2016,旅游
他们以前年轻,自由,单身男人一起旅行过,尽管这些日子他们都和小孩结婚,享受家庭生活。但现在他们有机会摆脱现代中产阶级的压力,摆脱自由的斗篷,成为他们曾经的自由精神。我们的两个Amigos正在离开家中的舒适,学习高棉的方式 - 阿根廷崎岖的牛仔,国家的图标和自由和勇气的体现。
电影
超清

2024/日本/日本,2016,动物
平静的英国田野,放眼望向草地就会发现英国最常见的哺乳动物——野兔,在草地上生活看似很安详,但这些长耳朵的动物每天都要为生存而奋斗,和它们分享这片草地的是虽小但凶猛的动物——白鼬!虽然白鼬的速度快且敏捷,但野兔数量多,而且合作默契!
电影
超清

2013/美国/美国,2016,动物
在荒芜严苛的那米比沙漠(Namib Desert)有大大小小的猎者。一群勇敢的狐蒙(Meerkats)在这里挣扎求生。牠们必须面对胡狼(jackals)、蛇和猛禽的威胁,还要忍受严酷的沙漠气候。
电影
超清

2024/英国/英国,2016,灾难
在世界上最严重的石油泄漏事故一年后英国石油公司再次深陷泥潭,公司在俄罗斯境内开展的北极石油勘探项目前途莫测,本片将探索英国石油公司的操作模式,公司是否获得了特别优待?其倒闭是否是国家不能承受之重?
电影
超清

2024/大陆/内地,2016,军事
18岁的农家男孩龚守庆,即将告别亲人,在接下来的三个月里,他将接受一支神秘部队——原北京军区特种作战旅的训练。在这里,他将要经历中国特种兵残酷的初期选拔淘汰训练和之后严酷的实战技能训练。龚守庆能否通过层层选拔,最终实现自己成为一种特种兵的梦想呢?通过跟踪拍摄龚守庆的成长脚步,本片首次展示了特种兵艰辛的成长历程以及背后鲜为人知的动人故事。
电影
超清

2015/美国/美国,2017,科技
随着YouTube变成十位,我们通过世界上最知名的视频分享网站的镜头图表在过去十年的历史。这是历史上规模最大,最有影响力的病毒视频里面的故事,而这个平台的,从初创翻红主要企业的球员。这是那些谁创造了它的人的故事,明星才催生的,其命运的国家,它改变了。2005年的第一个YouTube视频的4月23日,“我见面,在动物园”为特色的联合创始人贾韦德·卡里姆,被上传。十年后,视频共享平台利用,已经改变了世界-transforming流行文化,政治改写的规则,推翻政府,重新定义新闻的本质,揭露我们所有人的调整动力,板材,精神科,Beiber,而在汽车上ROBO-VAC鲨鱼装。这是怎么回事,在十年间发生的故事。
电影
超清

2015/美国/美国,2017,旅游
这是科斯塔雪姬,最大的船舶在欧洲的一个故事。与我们一起尽享不同的冒险 从应急演练,以令人难忘的生日。\r\n这个迷人的六部分系列的特点哥斯达黎加小威,欧洲最大的邮轮之一。超过伦敦桥和覆盖更多的空间比20个足球场娱乐区更长的时间,她的1000强的工作人员推到了极致保持有大约3800名乘客在办理入住手续。按照海上所有的行动作为队长的意大利鲁索和他的船员应对恶劣天气,挑剔的客人,古怪的艺人和医疗紧急情况的冲击。期待探戈,脾气,争吵和生日-这是游轮生活的内情。
电影
超清

2017/大陆/内地,2017,政治
中国与哈萨克斯坦是友好邻邦,从古老丝绸之路的历史渊源,到丝绸之路经济带的核心位置,凝聚着古往今来相互交往的传奇故事。纪录片《光阴的故事-中哈友好》是中哈联合摄制的,本片于习主席出访哈萨克斯坦参加“阿斯塔纳世博会”期间,配合“上合会议”于6月8日-9日晚间,在中国中央电视台和哈萨克斯坦国家电视台同步播出。该片是两国制作团队的智慧结晶,也是两国媒体首次深度的合作。系列片分为上下两集,每集52分钟,以双方差异化的视角,共同解读从历史到现在,从政府到民间,彼此的认知与合作,通过多领域丰富生动的故事,展现了中哈两国依托历史,立足当下,携手未来的发展前景,体现了两国人民真挚的情感,见证了一带一路的发展态势,使两个国家能够拥有更加灿烂美好的未来。
电影
超清

2024/美国/美国,2017,美食
主持人基蓝杰斯瓦走遍全球,探索各种独特食材和极端的采收方式。基蓝杰斯瓦,旅行到了玻利维亚,加入一场有致命危险的收成,采收世界上非常具争议性的植物,古柯叶,也就是制作古柯硷的主要原料。还冒险前往正值隆冬的中国东北部,寻找莲藕和巨鲤这两种中国珍馐。
电影
超清

2011/英国/英国,2017,旅游
美国最大的河流系统,以及银行所培育的壮观景观,多元文化遗产和工业胜利。 继秘密地中海的成功之后,特雷弗·麦克唐纳爵士将从墨西哥湾到加拿大附近的密西西比河源头进行史诗般的旅程。 包括好莱坞电影巨星摩根·弗里曼(Morgan Freeman)和埃尔维斯·普雷斯利(Elvis Presley)的前女友芭芭拉·赫恩(Barbara Hearn)在内的迷人人物,证明了密西西比所创造的独特氛围。 这次旅行揭示了强大的河流如何影响美国的文化和政治,从国家诞生到今天。
电影
超清

2013/英国/英国,2018,科学
我们都是人,我们都会犯错误,我们都犯过错误。我们对此无能为力-或者说,也不尽然?凯文·方博士展示了最新的科学如何将我们对于人类的理解进行彻底颠覆,并为我们保留了在生死攸关时让少犯错误的希望-从最前沿的神经系统科学到新近对于人类大脑如何处理压力的发现。人类都会犯错,但无需为此付出生命的代价。这门新兴的科学为我们带来了如何降低错误代价的方法。
电影
超清

2018/日本/日本,2018,社会
忍者是日本的经典人物。他们在战国时期,大约500年前就活跃起来了,但几个世纪以后,一个忍者还在我们身边。现年84岁的Masaaki Hatsumi是Togakure学校的继任者。他为世界各地的十多万学生提供了一种最高形式的自我防卫,包括联邦调查局特工和军队人员。 Hatsumi可以很容易地抵挡弟子的攻击,使他们只用一根手指不能移动。他惊人艺术的本质是什么?本片调查了这个忍者大师的隐藏力量。
电影
超清

2024//纪录
本课程持续更新中,全集16集。《清谈财富》是由腾讯视频与如是金融研究院联合推出的财富增值课。经济学家管清友将从宏观经济运行模式、国际与国内形势,到房地产、基金、股票等各大类资产配置,将自己对投资的思考传授给大家。本课程将通过管清友老师的讲述,助你建立属于自己的分析框架、投资逻辑,带你做出当下最正确的财富增值选择。
电影
超清

2020/大陆/内地,2020,社会
由《我住在这里的理由》导演竹内亮所拍摄纪录片。以一个外国人的视角,见证了疫情之下中国的点点滴滴:从衣食起居到工作学习。展现了南京,这座持续数天感染者为0的城市,在严格遵守政府为抗击新冠肺炎疫情而制订的各项防控措施的情况下,人们生活与工作的日常。